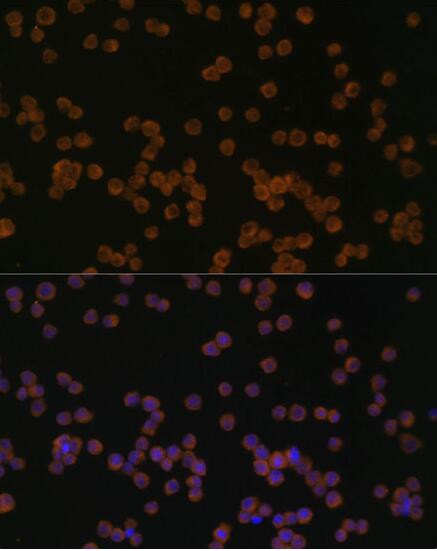
CHI3L1 Antibody in Immunocytochemistry (ICC/IF)

Search
Invitrogen
CHI3L1 Polyclonal Antibody
{{$productOrderCtrl.translations['antibody.pdp.commerceCard.promotion.promotions']}}
{{$productOrderCtrl.translations['antibody.pdp.commerceCard.promotion.viewpromo']}}
{{$productOrderCtrl.translations['antibody.pdp.commerceCard.promotion.promocode']}}: {{promo.promoCode}} {{promo.promoTitle}} {{promo.promoDescription}}. {{$productOrderCtrl.translations['antibody.pdp.commerceCard.promotion.learnmore']}}







Please note: We are reviewing Western blot images included in the antibody testing data in our catalog, including those provided by third parties. Unless expressly labeled or annotated as “raw-unedited”, Western blot images included in the antibody testing data in our catalog may have been edited, optimized or otherwise adjusted for presentation.
产品信息
PA5-37357
种属反应
宿主/亚型
分类
类型
抗原
偶联物
形式
浓度
规格
纯化类型
保存液
内含物
保存条件
运输条件
RRID
产品详细信息
This antibody detects endogenous protein at a molecular weight of 43 kDa.
Purity is >95% by SDS-PAGE.
靶标信息
Human cartilage glycoprotein 39 (GP-39), also known as YKL-40, is a glycoprotein secreted by articular chondrocytes, synoviocytes and macrophages. Serum and synovial fluid GP-39 levels are elevated in inflammatory diseases and correlate with the degree of joint destruction in rheumatoid arthritis. GP-39 is expressed in articular chondrocytes and synovial cells, as well as in liver, but is undetectable in muscle tissues, lung, pancreas, mononuclear cells and fibroblasts. GP-39 is a candidate autoantigen in rheumatoid arthritis and is important in the capacity of cells to respond to and cope with changes in their environment.
仅用于科研。不用于诊断过程。未经明确授权不得转售。
生物信息学
蛋白别名: 39 kDa synovial protein; Breast regression protein 39; BRP39 protein; Cartilage glycoprotein 39; CGP-39; CGP39; Chitinase 3 like protein 1CGP 39; chitinase 3-like 1; chitinase 3-like 1 (cartilage glycoprotein-39); chitinase 3-like 1 protein; Chitinase-3-like protein 1; DKFZp686N19119; FLJ38139; GP-39; hCGP39; unnamed protein product; YKL-40
基因别名: ASRT7; AW208766; Brp39; CGP-39; CHI3L1; Chil1; GP-39; GP39; HC-gp39; hCGP-39; HCGP-3P; YK-40; YKL-40; YKL40; YYL-40
UniProt ID: (Rat) Q9WTV1, (Mouse) Q61362
Entrez Gene ID: (Human) 1116, (Rat) 89824, (Mouse) 12654